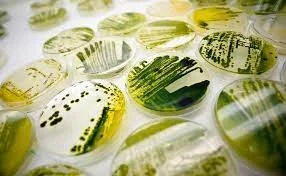

Press
-

-

-

-

-

-

-

-

-

-

-

WALL STREET JOURNAL
-

-

-

-

WALL STREET JOURNAL
-

NEW YORK MAGAZINE
-

-

-
NEW YORK TIMES
Press Release Writing Examples
-
Molekule's PECO Air Purification Technology Effectively Captures and Destroys SARS-CoV-2, the COVID-19 virus, New Study Shows
-
Molekule Air Pro Air Purifier Receives FDA Clearance for the Destruction of Viruses, Bacteria, and Mold
-
Molekule Announces Publication Of Peer-Review Journal Article in The Journal of Indoor Air
-
Molekule Named Official Air Purification Partner of Madison Square Garden Arena